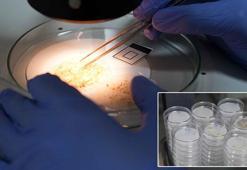
Mikroplastik tehlikesi gözle görülmüyor, hayatı tehdit ediyor

Mikroplastik
Son dakika mikroplastik haberleri ile ilgili DHA'ya eklenen tüm haberler bu sayfada yer almaktadır. Geçmişte yaşanan mikroplastik gelişmeleri, bugün yaşanan en flaş gelişmeler ve çok daha fazlası sürekli güncel olan mikroplastik haber sayfamızda...
Mikroplastik
haber başlıkları altta listelenmiştir. Son dakika haberleri de dahil olmak üzere şu ana kadar eklenen toplam 155 mikroplastik haberi bulunmuştur.
Tek kullanımlık plastik yönetmeliğine uzmanından ‘üretim kısıtlaması’ önerisiMİKROPLASTİK Araştırma Grubu Kurucusu ve Sabancı Üniversitesi İstanbul Politikalar Merkezi’nde görevli Prof. Dr. Sedat Gündoğdu, tek kullanımlık plastiklerin piyasaya arzının kısıtlanmasının Türkiye’nin COP31 İklim Zirvesi’ndeki pozisyonunu güçlendireceğine dikkat çekerek, “Taslak metinde görmediğimiz en önemli yaklaşım, üretimin kısıtlanması ve yasaklanması meselesidir. Taslak nihai haline getirildiğinde bu durumun da göz önüne alınmasını bekliyoruz” dedi.
16.04.2026Video

Tek kullanımlık plastik yönetmeliğine uzmanından ‘üretim kısıtlaması’ önerisiMikroplastik Araştırma Grubu Kurucusu ve Sabancı Üniversitesi İstanbul Politikalar Merkezi’nde görevli Prof. Dr. Sedat Gündoğdu, tek kullanımlık plastiklerin piyasaya arzının kısıtlanmasının Türkiye’nin COP31 İklim Zirvesi’ndeki pozisyonunu güçlendireceğine dikkat çekerek, “Taslak metinde görmediğimiz en önemli yaklaşım, üretimin kısıtlanması ve yasaklanması meselesidir. Taslak nihai haline getirildiğinde bu durumun da göz önüne alınmasını bekliyoruz” dedi.
16.04.2026Foto Galeri

Datça-Bozburun ÖÇKB'de 17 istasyonun tamamında mikroplastik tespit edildiMuğla'nın Datça ilçesi ile Bozburun Yarımadası'nı kapsayan Özel Çevre Koruma Bölgesi'nde (ÖÇKB) yapılan bilimsel araştırmada, 17 istasyonun tamamında mikroplastik kirliliği tespit edilirken, 1 metreküp deniz suyunda 931 parçacık bulunduğu belirlendi.
19.03.2026Gündem

Karadeniz'de 'sessiz katil hayalet ağlara' robotik müdahaleKaradeniz'de deniz kirliliğine neden olan ve biyoçeşitliliğe zarar veren 'sessiz katil hayalet ağlar' olarak adlandırılan atık balık ağlarının, ekosistem restorasyonuna etkisini, Karadeniz Teknik Üniversitesi'nden (KTÜ) bilim insanları, yenilikçi tekniklerle inceleyecek. 'ROWER' adlı yeni projeyle; su altı robotları ile hayalet ağların tespiti ve çıkarılması hedeflenirken, kamera ve yapay zeka destekli sistemlerle de su altındaki canlı çeşitliliği anbean izlenecek.
16.02.2026Video

'Anne sütünde dahi tespit edilen mikroplastikler çevreyi ve insan sağlığını tehdit ediyor'Çevre Mühendisleri Odası Yönetim Kurulu Üyesi Arzu Yücel, mikroplastiklerin anne sütü ve plasentada dahi tespit edildiğine dikkat çekerek, hızla artan plastik üretiminin hem çevreyi hem de insan sağlığını ciddi biçimde tehdit ettiğini söyledi.
25.12.2025Foto Galeri

Bakan Kurum: Tek kullanımlık plastiklerde kısıtlamaya gidiyoruzÇevre, Şehircilik ve İklim Değişikliği Bakanı Murat Kurum, "'Sıfır 'Atık vizyonumuzla tarihi bir adımı daha atıyoruz. Tek kullanımlık plastiklerde kısıtlamaya gidiyor, denizlere ve ekosisteme sahip çıkıyoruz" dedi.
15.08.2025Politika

Yüksek rakımdaki göllerde 1 metreküp suda 160 mikroplastik çıktıTürkiye'de plastik üzerine çalışma yürüten akademisyenler, yaklaşık 4 bin rakımdaki Kaçkar ve Keşiş Dağları'na ulaşıp buradaki buzul göllerini mikroplastik kirliliği açısından araştırdı. Çalışmada; insan aktivitesinin sınırlı olduğu bu alanlarda dahi 1 metreküp suda 160, 1 kilogram göl çamurunda 120 mikroplastik tespit edildi.
2.08.2025Video

Yüksek rakımdaki göllerde 1 metreküp suda 160 mikroplastik çıktıTürkiye'de plastik üzerine çalışma yürüten akademisyenler, yaklaşık 4 bin rakımdaki Kaçkar ve Keşiş Dağları'na ulaşıp buradaki buzul göllerini mikroplastik kirliliği açısından araştırdı. Çalışmada; insan aktivitesinin sınırlı olduğu bu alanlarda dahi 1 metreküp suda 160, 1 kilogram göl çamurunda 120 mikroplastik tespit edildi.
2.08.2025Foto Galeri
Mikroplastik tehlikesi gözle görülmüyor, hayatı tehdit ediyorAkdeniz Üniversitesi'nden Doç. Dr. Olgaç Güven, denizlerdeki plastik kirliliği ve mikroplastik tehdidine karşı uyarıda bulundu. Kirliliğin sadece çevresel değil, sosyoekonomik etkiler doğurduğuna dikkati çeken Doç. Dr. Güven, "Plastik yok olmuyor, parçalanıyor ve denizde kalıyor. Önlem almazsak besin zincirine kadar ulaşan kalıcı bir tehditle karşı karşıyayız" dedi.
22.07.2025Video

Mikroplastik tehlikesi gözle görülmüyor, hayatı tehdit ediyorAkdeniz Üniversitesi'nden Doç. Dr. Olgaç Güven, denizlerdeki plastik kirliliği ve mikroplastik tehdidine karşı uyarıda bulundu. Kirliliğin sadece çevresel değil, sosyoekonomik etkiler doğurduğuna dikkati çeken Doç. Dr. Güven, "Plastik yok olmuyor, parçalanıyor ve denizde kalıyor. Önlem almazsak besin zincirine kadar ulaşan kalıcı bir tehditle karşı karşıyayız" dedi.
22.07.2025Gündem

pladis Hızlandırma Programı’na katılacak 12 yenilikçi girişim belli olduYıldız Holding’in global atıştırmalık şirketi pladis ve Yıldız Ventures iş birliğiyle hayata geçirilen Hızlandırma Programı’na, dünyanın dört bir yanından 300’ü aşkın girişim başvurdu. Sağlık, sürdürülebilirlik ve içerik inovasyonu alanlarında öne çıkan 12 girişim seçildi. ‘pladis Accelerator Programme powered by Yıldız Ventures’ ismiyle düzenlenen program, 1 Temmuz – 30 Ağustos tarihleri arasında gerçekleşecek ve bu alanlarda çığır açan çözümler geliştiren girişimlere ölçeklenme desteği sunacak.
9.07.2025Ekonomi

'Cam şişe içerisinde tespit edilen partiküllerin mikroplastik olup olmadığı belli değil'Çukurova Üniversitesi'nden (ÇÜ) Prof. Dr. Sedat Gündoğdu, 'cam şişelerde daha fazla mikroplastik bulunduğu' yönündeki açıklamaların tedirginliğe yol açtığını belirterek, "Çalışmanın handikabı bazı markalarda cam şişe içerisinde tespit edilen partiküllerin yüzde 80 kadarının mikroplastik olup olmadığının tespit edilememiş olmasıdır. Bir mineral taneciği ya da insan kaynaklı da olsa mikroplastik olmayan parçacıklar, herhangi bir içeceğin içerisinde bulunabilir" dedi.
4.07.2025Video

'Cam şişe içerisinde tespit edilen partiküllerin mikroplastik olup olmadığı belli değil'Çukurova Üniversitesi'nden (ÇÜ) Prof. Dr. Sedat Gündoğdu, 'cam şişelerde daha fazla mikroplastik bulunduğu' yönündeki açıklamaların tedirginliğe yol açtığını belirterek, "Çalışmanın handikabı bazı markalarda cam şişe içerisinde tespit edilen partiküllerin yüzde 80 kadarının mikroplastik olup olmadığının tespit edilememiş olmasıdır. Bir mineral taneciği ya da insan kaynaklı da olsa mikroplastik olmayan parçacıklar, herhangi bir içeceğin içerisinde bulunabilir" dedi.
4.07.2025Gündem

Prof. Dr. Kadıoğlu: Kenelerin neden olduğu Lyme hastalığı konusunda uzman azTrabzon Kent Konseyi tarafından düzenlenen 'İklim Değişikliği ve Su Sempozyumu' ikinci gününde de sürdü. İstanbul Teknik Üniversitesi (İTÜ) Afet Yönetim Enstitüsü Müdürü Prof. Dr. Mikdat Kadıoğlu, Türkiye'de Lyme hastalığı konusunda uzmanın çok az olduğunu belirterek, "Keneler, Lyme hastalığı ya da Kırım Kongo Kanamalı Ateşi'ne neden oluyor" dedi.
25.06.2025Video

Prof. Dr. Kadıoğlu: Kenelerin neden olduğu Lyme hastalığı konusunda uzman azTrabzon Kent Konseyi tarafından düzenlenen 'İklim Değişikliği ve Su Sempozyumu' ikinci gününde de sürdü. İstanbul Teknik Üniversitesi (İTÜ) Afet Yönetim Enstitüsü Müdürü Prof. Dr. Mikdat Kadıoğlu, Türkiye'de Lyme hastalığı konusunda uzmanın çok az olduğunu belirterek, "Keneler, Lyme hastalığı ya da Kırım Kongo Kanamalı Ateşi'ne neden oluyor" dedi.
25.06.2025Gündem

Cam şişelerde mikroplastik oranı daha yüksek çıktıFransa'da yapılan araştırma, gazlı içecek veya çay cam şişelerde satılanlarında plastik ya da metal kutulara göre daha fazla mikroplastik bulunduğunu ortaya koydu.
25.06.2025Dünya

Uzmanından uyarı: Mikroplastikler sağlığı tehdit ediyorSu şişeleri, tabaklar ve solunan havada bile mikroplastiklerin sağlığı tehdit ettiğini söyleyen Kardiyoloji Uzmanı Prof. Dr. Bülent Demir, “Kalp, beyin ve böbreklerimizde bile var. Mikroplastikler sağlığı tehdit ediyor, sadece sindirim sistemiyle sınırlı kalmıyor. Kalbin çevresindeki yağ dokusunda, sol kulakçık içinde ve hatta doğrudan kalp kası içerisinde mikroplastiklere rastlandı. Vücut bu yabancı maddelere karşı iltihap yanıtı veriyor. Bu da damar plaklarının daha kırılgan hale gelmesine, dolayısıyla kalp krizine zemin hazırlıyor” dedi.
11.06.2025Sağlık-Yaşam

Flamingo ve kaplumbağaların yaşam alanı olan koruma altındaki lagünlerde plastik tehdidiAdana'da Çukurova Üniversitesi (ÇÜ) Su Ürünleri Fakültesi Öğretim Üyesi ve Mikroplastik Araştırma Grubu Kurucusu Prof. Dr. Sedat Gündoğdu, flamingo, kaplumbağalar ve balıkların yaşam alanı olan Akdeniz Bölgesi’ndeki lagünlerde yapılan mikroplastik kirliliğiyle ilgili araştırmanın sonuçlarını paylaşarak, “Tuzla Lagünü’nde litrede 60-70 arası mikroplastik tespit edildi. Bu sayı metreküpe vurulduğunda 60-70 bin adet mikroplastiğin varlığından bahsedebiliriz. Akyatan’da da benzer bir sonuç var. Burada gölün içerisindeki su miktarı dikkate alındığında mikroplastik miktarının trilyonlar, katrilyonlar seviyesine yükseldiğini söyleyebiliriz” dedi.
5.06.2025Video

Flamingo ve kaplumbağaların yaşam alanı olan koruma altındaki lagünlerde plastik tehdidiAdana'da Çukurova Üniversitesi (ÇÜ) Su Ürünleri Fakültesi Öğretim Üyesi ve Mikroplastik Araştırma Grubu Kurucusu Prof. Dr. Sedat Gündoğdu, flamingo, kaplumbağalar ve balıkların yaşam alanı olan Akdeniz Bölgesi’ndeki lagünlerde yapılan mikroplastik kirliliğiyle ilgili araştırmanın sonuçlarını paylaşarak, “Tuzla Lagünü’nde litrede 60-70 arası mikroplastik tespit edildi. Bu sayı metreküpe vurulduğunda 60-70 bin adet mikroplastiğin varlığından bahsedebiliriz. Akyatan’da da benzer bir sonuç var. Burada gölün içerisindeki su miktarı dikkate alındığında mikroplastik miktarının trilyonlar, katrilyonlar seviyesine yükseldiğini söyleyebiliriz” dedi.
5.06.2025Foto Galeri

Bilim insanları uyardı: Savaş ve mikroplastikler arıları tehdit ediyorBilim insanları, arı nüfusunun, savaşlar, mikroplastikler ve ışık kirliliği gibi yeni tehditlerle karşı karşıya olduğunu bildirdi.
22.05.2025Dünya

Okyanusun her katmanında mikroplastik bulunduYeni bir araştırma, mikroplastik kirliliğinin okyanusun tüm katmanlarına yayıldığını ortaya koydu.
5.05.2025Dünya

Araştırma: Havadaki mikroplastik kirliliği kuşların akciğerlerinde birikiyorBilim insanları, havadaki mikroplastik kirliliğinin kuşların akciğerlerinde biriktiğini açıkladı.
10.03.2025Dünya

Atık temizliği yapıp, 'Plastik Gerçekleri' raporu hazırladılarEkolojik Araştırmalar Derneği (EKAD) öncülüğünde iki yıldır sürdürülen 'Plastiksiz Kıyılar, Plastiksiz Sular' projesi kapsamında hazırlanan raporda; yıllık küresel üretim miktarı 380 milyon tonu aşan plastiklerin en az yarısının tek kullanımlık olduğu, 2039 yılına kadar iki kat artacağının öngörüldüğü kaydedildi.
27.02.2025Video

5 yılda 460 geri dönüşüm tesisinde yangın çıktı; sürpriz denetimler ve erken uyarı sistemi şartÇukurova Üniversitesi (ÇÜ) Su Ürünleri Fakültesi Su Ürünleri Temel Bilimleri Bölümü Öğretim Üyesi ve Mikroplastik Araştırma Grubu Kurucusu Prof. Dr. Sedat Gündoğdu, Türkiye'de son 5 yılda 460 geri dönüşüm tesisinde yangın çıktığını, bunların yanlış depolamadan ve erken uyarı sisteminin olmamasından kaynaklandığını bildirdi. Prof. Dr. Sedat Gündoğdu, "Bakanlık ve belediyelerin bu tesisleri bir kamu sorumluluğu olarak görüp, sahada sürpriz denetimlerle güncellenmiş yangın yönetmeliğine göre ilgili şartları taşıyıp taşımadığına bakması gerekiyor" dedi.
21.02.2025Video

5 yılda 460 geri dönüşüm tesisinde yangın çıktı; sürpriz denetimler ve erken uyarı sistemi şartÇukurova Üniversitesi (ÇÜ) Su Ürünleri Fakültesi Su Ürünleri Temel Bilimleri Bölümü Öğretim Üyesi ve Mikroplastik Araştırma Grubu Kurucusu Prof. Dr. Sedat Gündoğdu, Türkiye'de son 5 yılda 460 geri dönüşüm tesisinde yangın çıktığını, bunların yanlış depolamadan ve erken uyarı sisteminin olmamasından kaynaklandığını bildirdi. Prof. Dr. Sedat Gündoğdu, "Bakanlık ve belediyelerin bu tesisleri bir kamu sorumluluğu olarak görüp, sahada sürpriz denetimlerle güncellenmiş yangın yönetmeliğine göre ilgili şartları taşıyıp taşımadığına bakması gerekiyor" dedi.
21.02.2025Foto Galeri
